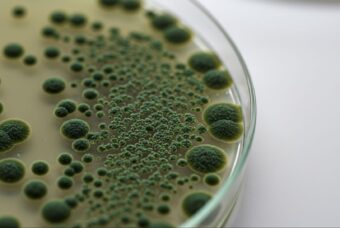

再発防止・予防・除湿対策
再発防止・予防・除湿対策
カビ原因調査を依頼する会社の選び方|カビ原因調査10,000件以上の専門家が解説
2026年03月17日
再発防止・予防・除湿対策
カビ原因調査に強い会社をお探しならハーツリッチにお任せください
2026年03月13日
再発防止・予防・除湿対策地域・地名別 カビの悩み・相談事例
【保存版】大阪・兵庫の湿気対策!梅雨を乗り切るカビ対策完全マニュアル
2025年02月04日
再発防止・予防・除湿対策地域・地名別 カビの悩み・相談事例
沖縄の湿度は80%超!?沖縄のカビ対策10選をカビ取りのプロが伝授
2023年06月27日
再発防止・予防・除湿対策施設・建物タイプ別カビ対策
これでマンションのカビの9割を予防できる!?マンションのカビ対策10選
2023年06月19日
再発防止・予防・除湿対策暮らしの場所別 カビ対策
地下室・半地下のカビとサヨナラ!正しいカビ取りとカビ対策をプロが教えます
2023年01月25日
再発防止・予防・除湿対策特定シーン/ユーザー別対策
新築はカビが発生しやすいって本当!?原因と対策をカビ取りのプロが徹底解説
2023年01月13日
再発防止・予防・除湿対策暮らしの場所別 カビ対策
【カビのプロが教える】クローゼットのカビ対策と最強のアイテム10選
2022年11月08日
再発防止・予防・除湿対策
プロが選ぶ!防カビ剤おすすめ6選|場所別に最適アイテムを紹介
2022年06月08日
再発防止・予防・除湿対策
【2026年版】梅雨から急増する“厄介なカビ”の撃退法と再発防止をプロが徹底解説
2019年05月16日
12